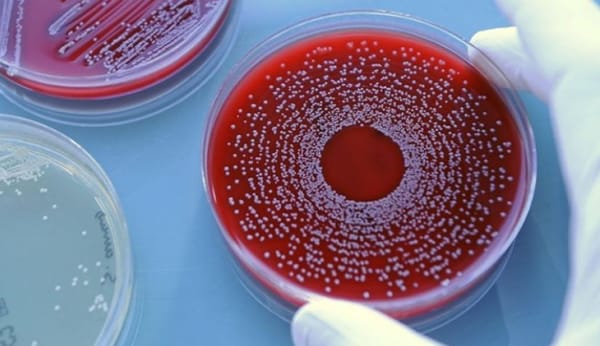
La pollution à l’origine de superbactéries mortelles, alerte l’ONU

L’Ukraine offre des subventions aux investisseurs alors qu’elle est en faillite
Par Ulrike Reisner- Journal de l’Empire des Habsbourg : pour plaire à Bruxelles, l’Ukraine veut atteindre la neutralité climatique d’ici 2050. Pour cela, des investissements importants sont nécessaires, mais ils se font actuellement attendre. L’Ukraine tente de pallier le manque d’intérêt des investisseurs par des primes d’alimentation financées par l’Etat. Mais le pays est en fait en faillite et n’est maintenue en vie que par des paiements et des garanties. C’est une farce grotesque qui se joue

courrier-strateges